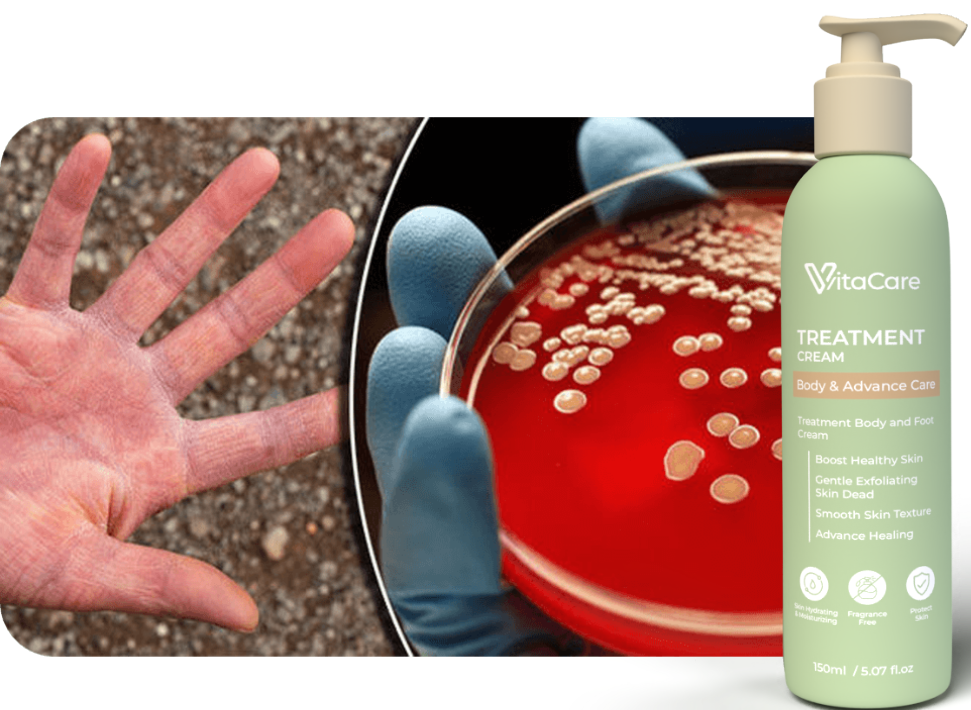

PALING SELAMAT & BERKESAN





Rasa gatal yang luar biasa dari dalaman, tak hilang walaupun digaru.

Kulit gatal menyebabkan bahagian kaki terlibat menjadi keras dan menggerutu

Kulit tidak normal menjadi merah, kering gatal dan berisisik

Jangkitan pada anggota badan akan sebabkan kulit mengalami keradangan.

Simptom ini terjadi adalah disebabkan jangkitan kulat

Perubahan warna kulit di bahagian kaki yang terlibat menjadi kehitaman atau pucat keputihan.







Tompokan gatal terjadi di kawasan tertentu anggota badan.

Hampir 30% kawasan badan mula dijangkiti masalah kegatalan

Kegatalan sudah merebak hampir 60% kawasan tubuh badan

Kegatalan semakin kritikal apabila mejangkiti hampir 100% kawasan tubuh badan dari kulit kepala hingga ke kaki







Mengikut satu kajian di Malaysia, kadar penyakit kulit semakin meningkat dan sangat membimbangkan. Penyakit ini akan menyerang tidak mengenal usia.

Dipercayai Lebih 86,598+ Pengguna


Rating dari ribuan pengguna
Pengguna kembali sihat
Selamat untuk diamalkan

Mengekalkan kelembapan semulajadi dan melindungi kulit dari pencemaran luaran

Anti-radang dan antioksidan, yang boleh membantu melegakan keradangan sendi.

Mengekalkan hidrasi kulit dengan menyerap lebihan minyak dan anti-inflamasi.

Meredakan gejala gatal, menyembuhkan luka dan radang pada kulit.

Membantu meningkatkan kemampuan sistem imun di dalam tubuh.
Menggunakan VERNONIA AMYGDALINA sebagai bahan utama yang turut dikenali sebagai “bitter leaf” dari Asia Tenggara dan Afrika.


Vitacare Menggunakan Bahan Utama Iaitu Madu Dan Propolis Yang Terbukti Secara Klinikal Untuk Membantu Merawat Dan Mempercepatkan Proses Penyembuhan Luka.
KAJIAN RUJUKAN : Elham Rasoulian , Mitra Zandi, Gholamreza Esmaeeli Djavid & Azam Malekiam (2021)
Penggunaan bahan Vernonia Amydalina atau bitter leaf bertindak sebagai agen Antioksida dan Antibakteria Untuk Mencegah Jangkitan Kuman Pada Luka.
KAJIAN RUJUKAN : Ebenezer O. Farombi,Olatunde Owoeye, Int. J. Environ. Res. Public Health 2011

Kebiasaannya Kulit Pesakit Ekzema Akan Mengalami Tompok-tompok Hitam Dan Kasar, Maka Kandungan Lactic Acid dalam Vitacare Berfungsi Untuk Menanggalkan Sel Kulit Mati.
KAJIAN RUJUKAN : Pascaline David, Seema Singh and Ruchira Ankar (2023)

Hampir 80% Pesakit Kulit Mengalami Komplikasi Masalah Kulit Kering, Bersisik, Gatal Dan Merekah. Aloe Vera Dan Ceramide dalam Vitacare Akan Memastikan Kulit Pesakit Sentiasa Dalam Kondisi Lembap dan Sihat
KAJIAN RUJUKAN : Younes Najafian, Zahra M Khorasani, Mona N Najafi, Shokouh S Hamedi, Marjan Mahjour, Zohre Feyzabadi 2019
Krim Vitacare Ini Selamat Digunakan Seluruh Anggota Badan Kecuali Mata & Mulut Sahaja.





Vitacare telah mendapat kelulusan dari KKM & Pensijilan dari Independent Lab bebas dari heavy metal, steroid, dadah dan kimia merbahaya.

Diformulasikan khas untuk memberi rawatan secara optimum kepada masalah gatal kulit, mencegah eczema, mengelakkan jangkitan kuman dan bakteria, anti fungus serta memberi kelembapan maksimum kepada kulit.





Menghilangkan kegatalan ekzema. Tidur jadi lena.

Vitacare berkesan menghilangkan kegatalan dan kulit gelap.

Berkesan menghilangkan kegatalan kulit berbanding ubat klinik.

Tiada Lagi Sakit Dan Tak perlu menggaru lagi akibat ekzema kronik

Kulit hampir pulih seawal 7 hari menggunakan Vitacare.

Tiada lagi tangisan anak akibat kegatalan ekzema.
Konsisten guna Vitacare memberikan kesan positif dengan menghilangkan kegatalan. Kulit hitam berkurangan. Sekarang saya dapat fokus bekerja. Tidur pun jadi lena.
Walaupun tanpa streoid, Vitacare terbukti berkesan menghilangkan kegatalan akibat ekzema tanpa mengeluarkan ribuan ringgit.




Kempen Berlangsung Sehingga 31 Mei 2024!








KLIK butang di bawah untuk bantuan segera dari team Customer Service kami:

Dayana Soffiya
Customer Service Expert
Boleh ! Krim ini sesuai untuk semua golongan kerana menggunakan bahan botanic dan boleh digunakan di anggota badan juga untuk merawat kulit kering serta gatal.